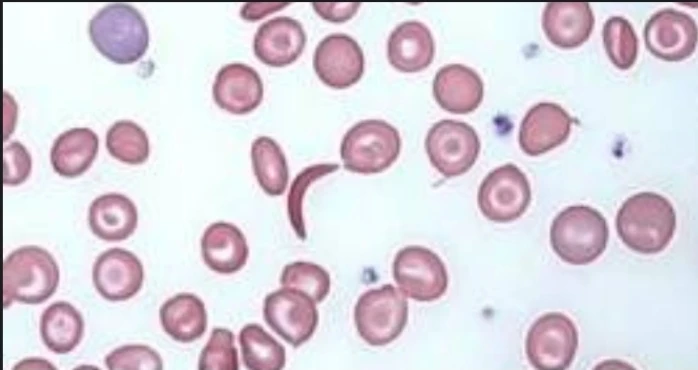
Sickle Cell Screen Test

تفاصيل التحليل
فحص خلايا الدم المنجلية (Sickle Cell Screen)
اختبار سريع وفعال للكشف عن وجود هيموجلوبين الخلايا المنجلية، ضروري جداً للفحص قبل الزواج وللتأكد من الحالة الوراثية لضمان مستقبل صحي لعائلتك.
الصورة التوضيحية المرتبطة بهذا التحليل